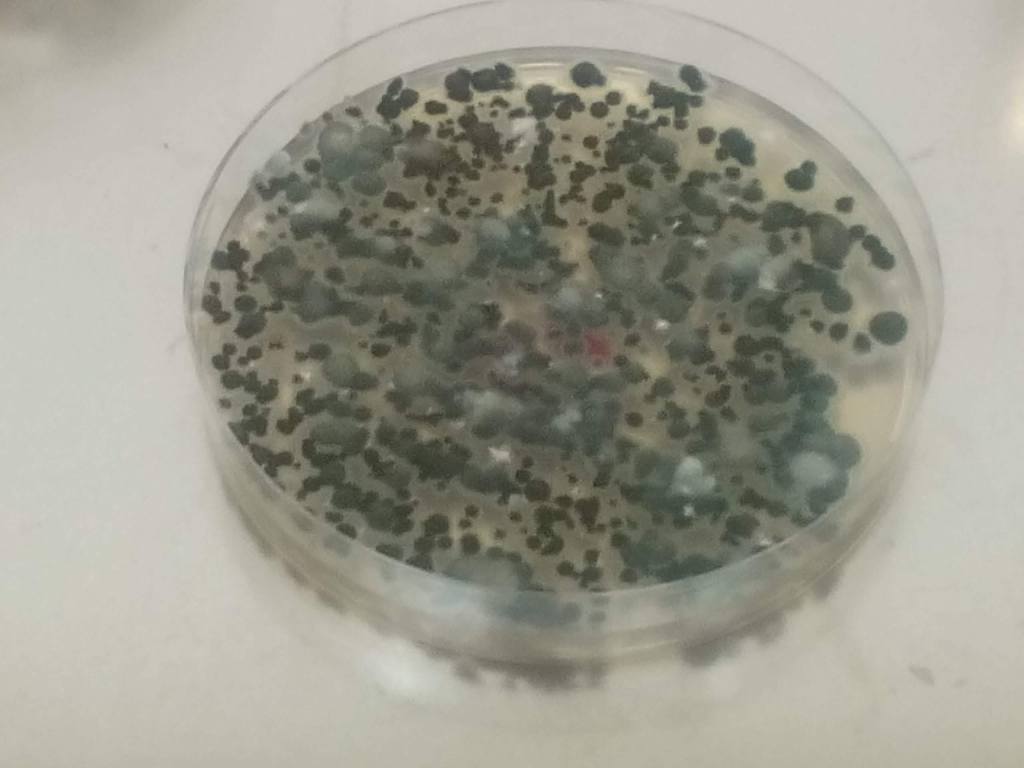
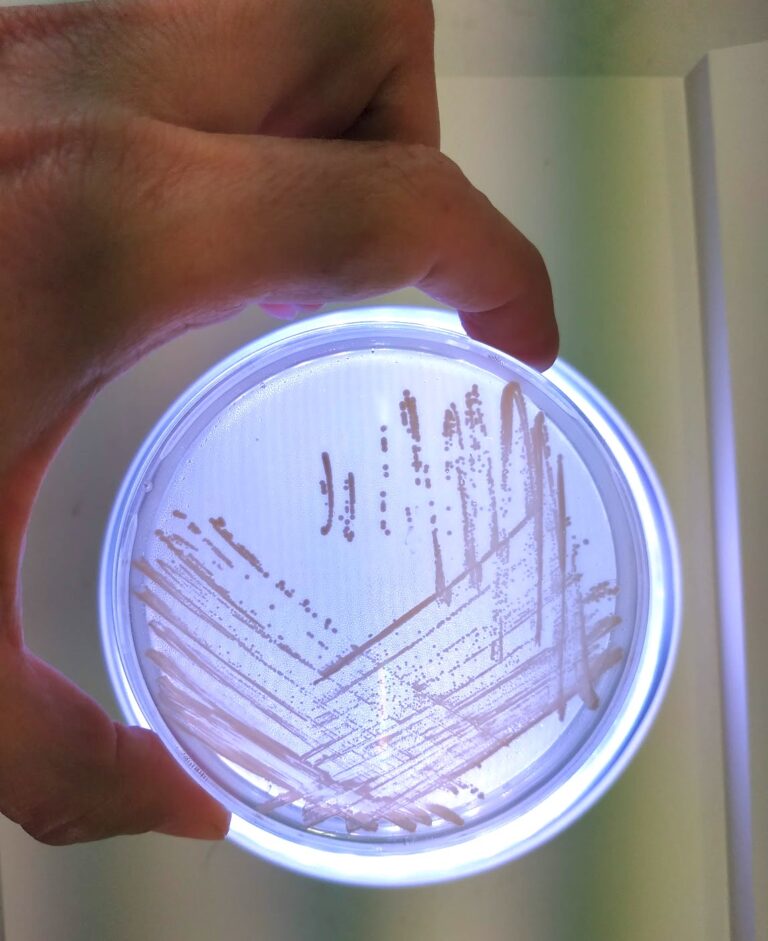

Na této stránce naleznete pracoviště z Vysoké školy chemicko-technologické Praha
Ing. Jana Bartáčková, Ph.D. – Ústav Technologie vody a prostředí
jana.bartackova@vscht.cz
+420 220 443 157

Mým hlavním cílem je zajistit plně funkční chromatografické a analytické metody (GC, UHPLC, ICP-OES, Gallery) na našem pracovišti. Od roku 2021 se zaměřuji také na Waste Water Based Epidemiology WBE. Bereme odpadní vodu jako zdroj informací o konkrétní populace a šíření mikropolutantů, virů, genů antibiotické resistence v prostředí. Díky projektům jsme sledovali a sledujeme geny resistence v odpadních čistírenských kalech, na přítoku a odtoku z čistíren a ve vodním prostředí.
doc. Ing. Jana Viktorová, Ph.D. a laboratoř adjuvantní terapie – Ústav biochemie a mikrobiologie
prokesoj@vscht.cz,
+420 220 444 335

Léková rezistence představuje závažný problém současnosti. Jelikož vývoj nových léčiv již není dostatečně progresivní vzhledem k rychlosti rozvoje rezistence, je nutné hledat alternativní řešení léčby. Takovouto alternativu může představovat adjuvans – látka navracející účinnost starým, nefunkčním léčivům, ke kterým je již rozvinutá rezistence známým mechanismem. Naše laboratoř se zabývá hledáním nových adjuvans pro léčbu bakteriálních infekcí a nádorových onemocnění. Již více než 40 let je v klinické praxi využíván Augmentin, který je kombinací amoxicilinu (β-laktamové antibiotikum) a kyseliny klavulanové (adjuvans inhibující β-laktamasy). Za tuto dobu prokázal svou účinnost, užitečnost a minimální rozvoj rezistence. Další adjuvans β-laktamů brzy následovala. Překvapivě jsou však inhibitory β-laktamas jedinými adjuvans schválenými pro adjuvantní terapii v současné době i přesto, že enzymů, které modifikují strukturu antibiotik (destruktas) je známa již celá řada. Toto otvírá prostor pro hledání nových účinných inhibitorů dalším bakteriálních destruktas.
Více